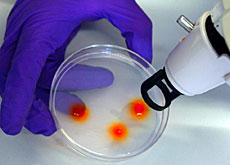

遺伝子で特許法見直し議論開始 製薬業界は反発
バイオテクノロジーは、遺伝子を利用して新たに医薬品や農作物などを開発する先端技術。バイオ産業の急成長を背景に、スイス連邦政府が示した遺伝子特許法原案が波紋を広げている。
内容は、遺伝子の発見者に特許(独占的使用権)が与えられる一方、遺伝子に関する情報開示を義務づけ、特許の対象となる遺伝子の機能もある程度限定する——などが柱だ。
これに対し、製薬業界の反応は冷ややかだ。特許を武器にした遺伝子ビジネスに力を注ぐ立場から、政府案は「特許保護が手薄い」と批判。また、非政府組織(NGO)は生命の特許化が様々な問題を引き起こすと危惧する一方で、政府案をある程度評価している。政府は10月末には法案としてまとめる方針だ。
保護か規制か
スイスはバイオ分野の企業が集まる国際拠点で、国内にあるバイオ関連企業の数は227社に上る。同国のバイオ産業全体の総売上高は欧州域内で6位、全世界でも9位とトップレベル。バイオ事業に力を入れる製薬業界は解読した遺伝子を特許化できれば、遺伝子ビジネスで独占的権利を行使できるという狙いがある。
国内の製薬業界を束ねる団体「インターファルマ」のトーマス・クエ二会長は、政府案に難色を示している。
「遺伝子ビジネスを手厚く保護している米国や他の欧州諸国の特許法に比べ、政府案は特許が侵害された際の保護が手薄い。スイスをバイオ産業の拠点にするという国のメッセージは全く伝わってこない」と同会長は話す。
また、政府案は特定遺伝子を発見した場合、発見者はどのようにしてその遺伝子を見つけたかなどの情報を公開することを義務づけており、製薬業界には受け入れがたい内容だ。遺伝情報を公知の事実にしてしまうと、知的財産権が侵され、企業の利益に反するとみているためだ。
一方、NGO「ベルン宣言」のフランソワ・マイエンバーグ氏は「特許化が進めば、研究者はすでに特許が認められた分野での研究に積極的でなくなってしまう」と話す。開発した医薬品を販売しようとしても特許侵害を理由に差止められたり、高額な特許使用料を要求されたりして、遺伝子ビジネスにつなげるのが難しいためだ。
それでも同氏は、政府案を概ね評価する考えだ。政府の原案には遺伝子に関する情報開示の義務づけ、特許を認める対象を限定する内容などがあり、特許化の動きをある程度規制する効果も期待できるとみる。
「今回の政府案はあるべき道筋の第一歩。バイオ産業の時代が到来しているのに、それを規制する法律がなければ、状況はさらに悪化するだけだ」と同氏は話している。
スイス国際放送 イソベル・レイボルド—ジョンソン 安達聡子(あだちさとこ)意訳
バイオ技術の進展で遺伝子の解読が加速化。
遺伝子治療や遺伝子組み換えなど、医療や農業への応用が期待されている。

JTI基準に準拠
swissinfo.chの記者との意見交換は、こちらからアクセスしてください。
他のトピックを議論したい、あるいは記事の誤記に関しては、japanese@swissinfo.ch までご連絡ください。